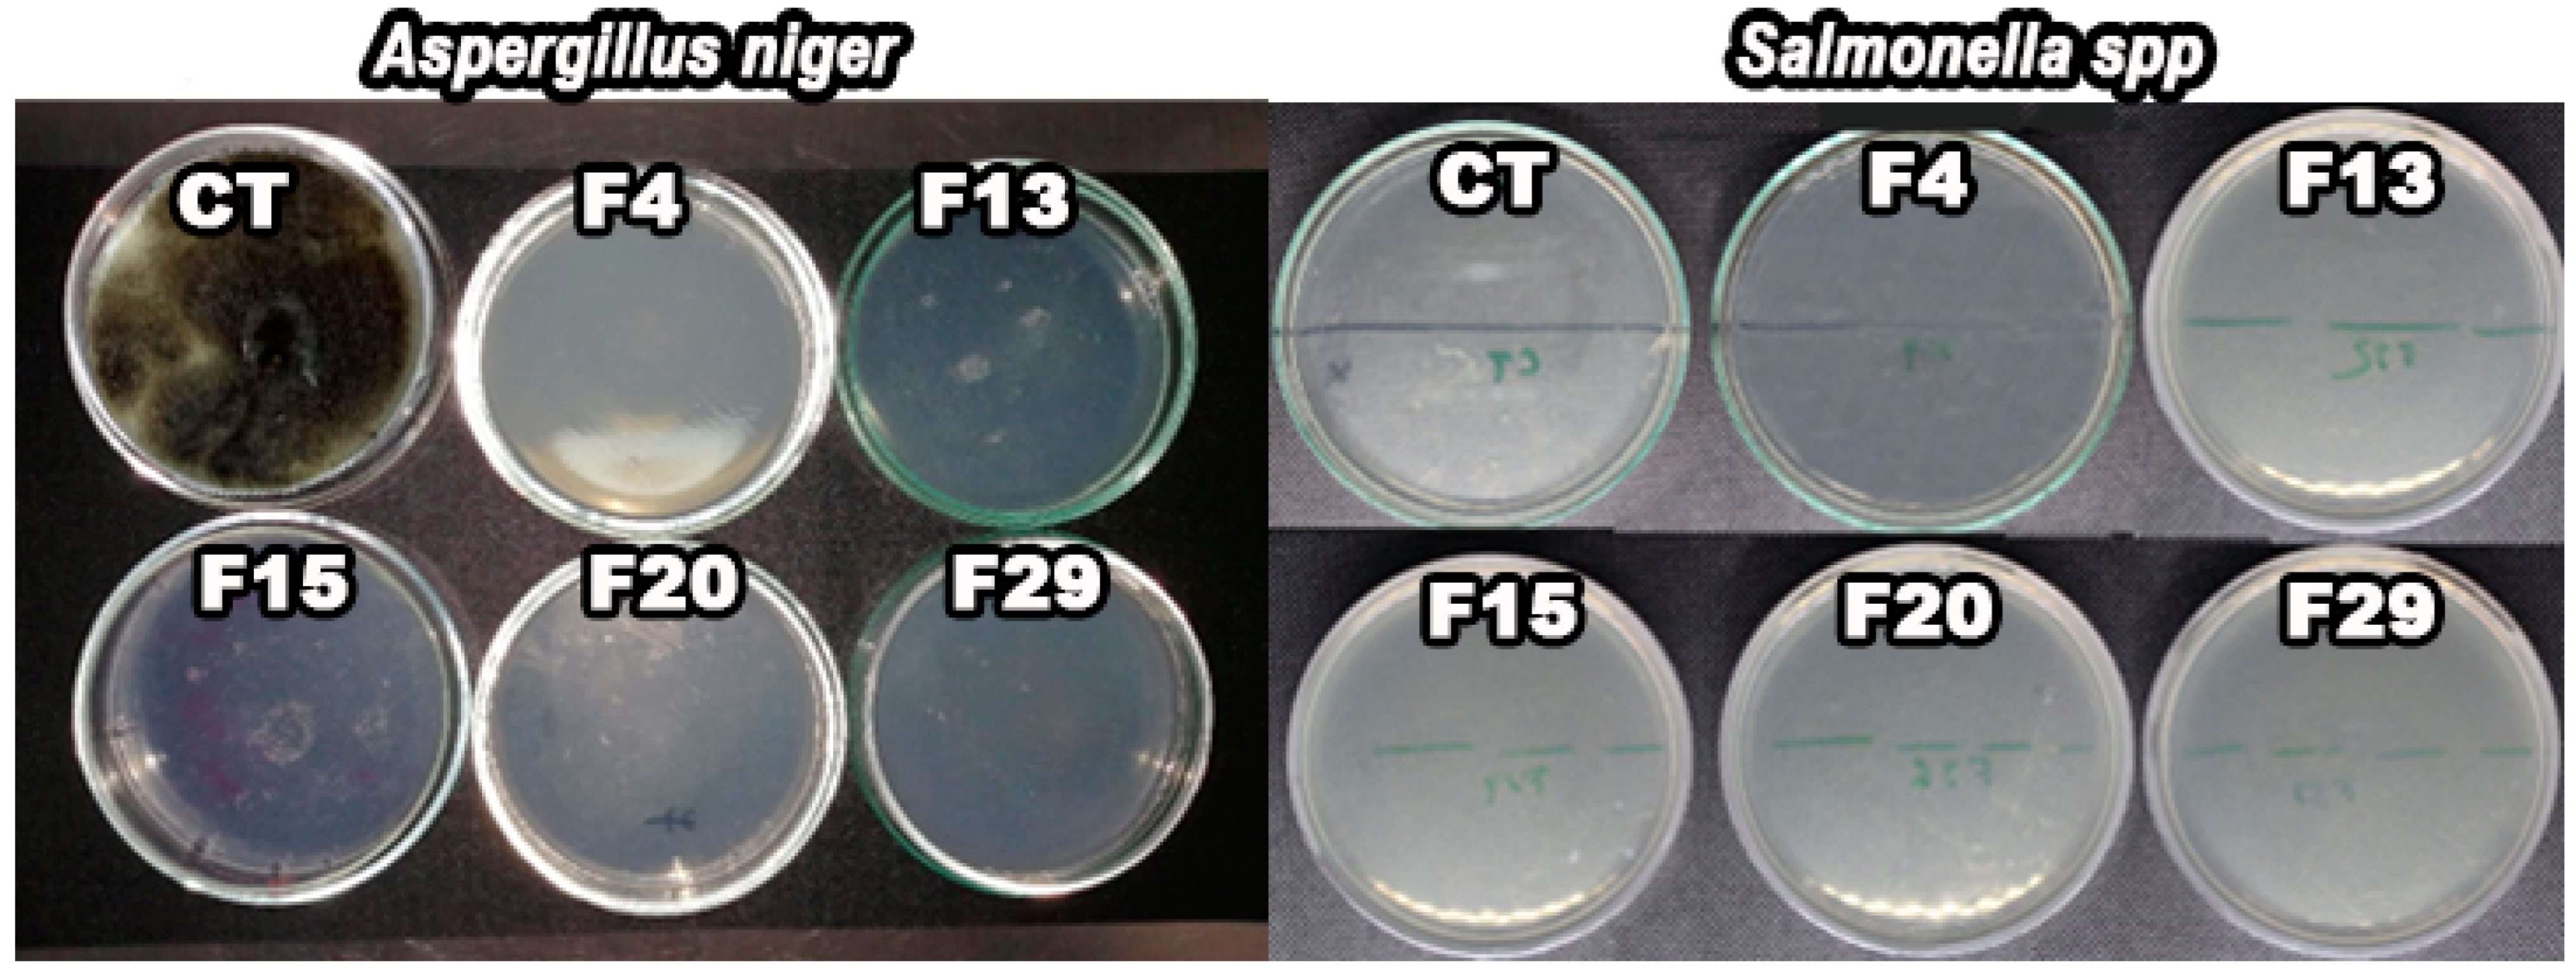
Coatings 14 01525 g005

Development of Edible Coatings Based on Different Biopolymers to Enhance the Internal Shelf-Life Quality of Table Eggs
Abstract
1. Introduction
2. Materials and Methods
2.1. Preparation and Application of Coating Solutions
2.2. Screening of Coatings on the Basis of Water Loss
2.3. Egg Quality Determination
2.3.1. Haugh Unit (HU)
2.3.2. Yolk Index (YI)
2.3.3. Air Chamber
2.3.4. pH Measurements
2.3.5. Water Vapor Transmission Rate (WVTR)
2.3.6. Scanning Electron Microscopy (SEM) of Eggshell Samples
2.3.7. Microbiology Test
2.4. Data Analysis
3. Results
3.1. Determination of Weight Loss
3.2. Determination of HU Values
3.3. Determination of the YI Parameter
3.4. Measurement of the Air Chamber
3.5. Determination of the pH of Yolk and Albumen
3.6. Determination of the WVTR and WVP
3.7. Morphology of Eggshells
3.8. Barriers to Microorganisms
4. Conclusions
Author Contributions
Funding
Institutional Review Board Statement
Informed Consent Statement
Data Availability Statement
Acknowledgments
Conflicts of Interest
References
- Abeyrathne, E.D.N.S.; Lee, H.Y.; Ahn, D.U. Egg White Proteins and Their Potential Use in Food Processing or as Nutraceutical and Pharmaceutical Agents—A Review. Poult. Sci. 2013, 92, 3292–3299. [Google Scholar] [CrossRef] [PubMed]
- Yüceer, M.; Caner, C. The Effects of Ozone, Ultrasound and Coating with Shellac and Lysozyme–Chitosan on Fresh Egg during Storage at Ambient Temperature—Part 1: Interior Quality Changes. Int. J. Food Sci. Technol. 2020, 55, 259–266. [Google Scholar] [CrossRef]
- FAOSTAT. Database, Food and Agriculture Organization of the United Nations Statistical. Available online: https://www.fao.org/faostat/en/#data (accessed on 3 August 2022).
- Conway, A. Global Poultry and Egg Market Projections. WATT Global Media. 2021. Available online: https://www.wattagnet.com/egg/egg-production/article/15504995/global-poultry-and-egg-market-projections (accessed on 20 November 2024).
- Xu, D.; Wang, J.; Ren, D.; Wu, X. Effects of Chitosan Coating Structure and Changes during Storage on Their Egg Preservation Performance. Coatings 2018, 8, 317. [Google Scholar] [CrossRef]
- Deng, B.; Wang, Z.; Xiao, N.; Guo, S.; Chen, L.; Mou, X.; Ai, M. Storage Deterioration and Detection of Egg Multi-Scale Structure: A Review. Food Chem. 2025, 464, 141550. [Google Scholar] [CrossRef] [PubMed]
- Adesiyun, A.A.; Nkuna, C.; Mokgoatlheng-Mamogobo, M.; Malepe, K.; Simanda, L. Food Safety Risk Posed to Consumers of Table Eggs from Layer Farms in Gauteng Province, South Africa: Prevalence of Salmonella Species and Escherichia Coli, Antimicrobial Residues, and Antimicrobial Resistant Bacteria. J. Food Saf. 2020, 40, e12783. [Google Scholar] [CrossRef]
- Qiu, J.L.; Zhou, Q.; Zhu, J.M.; Lu, X.T.; Liu, B.; Yu, D.Y.; Lin, G.; Ao, T.; Xu, J.M. Organic Trace Minerals Improve Eggshell Quality by Improving the Eggshell Ultrastructure of Laying Hens during the Late Laying Period. Poult. Sci. 2020, 99, 1483–1490. [Google Scholar] [CrossRef]
- De Brito Mota, A.S.; Da Silva Lima, P.M.; Silva, D.S.; Abreu, V.K.G.; Freitas, E.R.; Pereira, A.L.F. Internal Quality of Eggs Coated with Cassava and Yam Starches. Rev. Bras. Cienc. Agrar. 2017, 12, 47–50. [Google Scholar] [CrossRef]
- Dhumal, C.V.; Sarkar, P. Composite Edible Films and Coatings from Food-Grade Biopolymers. J. Food Sci. Technol. 2018, 55, 4369–4383. [Google Scholar] [CrossRef]
- Pires, P.G.d.S.; Bavaresco, C.; Leuven, A.F.R.; Gomes, B.C.K.; de Souza, A.K.; Prato, B.S.; Kindlein, L.; Andretta, I. Plasticizer Types Affect Quality and Shelf Life of Eggs Coated with Rice Protein. J. Food Sci. Technol. 2020, 57, 971–979. [Google Scholar] [CrossRef]
- Sanyang, M.L.; Sapuan, S.M.; Jawaid, M.; Ishak, M.R.; Sahari, J. Effect of Glycerol and Sorbitol Plasticizers on Physical and Thermal Properties of Sugar Palm Starch Based Films. In Recent Advances in Environment, Ecosystems and Development Effect; WSEAS: Attica, Greece, 2015; pp. 157–162. [Google Scholar]
- Priya, K.; Thirunavookarasu, N.; Chidanand, D.V. Recent Advances in Edible Coating of Food Products and Its Legislations: A Review. J. Agric. Food Res. 2023, 12, 100623. [Google Scholar] [CrossRef]
- Caner, C.; Yüceer, M. Efficacy of Various Protein-Based Coating on Enhancing the Shelf Life of Fresh Eggs during Storage. Poult. Sci. 2015, 94, 1665–1677. [Google Scholar] [CrossRef]
- Xu, L.; Zhang, H.; Lv, X.; Chi, Y.; Wu, Y.; Shao, H. Internal Quality of Coated Eggs with Soy Protein Isolate and Montmorillonite: Effects of Storage Conditions. Int. J. Food Prop. 2017, 20, 1921–1934. [Google Scholar] [CrossRef]
- Pires, P.G.S.; Machado, G.S.; Franceschi, C.H.; Kindlein, L.; Andretta, I. Rice Protein Coating in Extending the Shelf-Life of Conventional Eggs. Poult. Sci. 2019, 98, 1918–1924. [Google Scholar] [CrossRef]
- Esin, D.; Özlem, T. Effect of Chitosan Coatings on Quality and Shelf-Life of Chicken and Quail Eggs. Afr. J. Food Sci. 2022, 16, 63–70. [Google Scholar] [CrossRef]
- Rachtanapun, P.; Homsaard, N.; Kodsangma, A.; Leksawasdi, N.; Phimolsiripol, Y.; Phongthai, S.; Khemacheewakul, J.; Seesuriyachan, P.; Chaiyaso, T.; Chotinan, S.; et al. Effect of Egg-Coating Material Properties by Blending Cassava Starch with Methyl Celluloses and Waxes on Egg Quality. Polymers 2021, 13, 3787. [Google Scholar] [CrossRef]
- Biladeau, A.M.; Keener, K.M. The Effects of Edible Coatings on Chicken Egg Quality under Refrigerated Storage. Poult. Sci. 2009, 88, 1266–1274. [Google Scholar] [CrossRef]
- Farnejad, S.; Nouri, M.; Saeed, S. Obtaining of Chickpea Protein Isolate and Its Application as Coating Enriched with Essential Oils from Satureja Hortensis and Satureja Mutica in Egg at Room Temperature. Int. J. Food Sci. Technol. 2022, 50, 400–407. [Google Scholar] [CrossRef]
- Yuceer, M.; Caner, C. Antimicrobial Lysozyme-Chitosan Coatings Affect Functional Properties and Shelf Life of Chicken Eggs during Storage. J. Sci. Food Agric. 2014, 94, 153–162. [Google Scholar] [CrossRef] [PubMed]
- USDA. What Are the Egg Grades? Available online: https://ask.usda.gov/s/article/What-are-the-egg-grades (accessed on 8 August 2023).
- da Silva Pires, P.G.; da Silva Pires, P.D.; Cardinal, K.M.; Bavaresco, C. The Use of Coatings in Eggs: A Systematic Review. Trends Food Sci. Technol. 2020, 106, 312–321. [Google Scholar] [CrossRef]
- Kim, Y.B.; Lee, S.Y.; Yum, K.H.; Lee, W.T.; Park, S.H.; Lim, Y.H.; Choi, N.Y.; Jang, S.Y.; Choi, J.S.; Kim, J.H. Effects of Storage Temperature and Egg Washing on Egg Quality and Physicochemical Properties. Discov. Appl. Sci. 2024, 6. [Google Scholar] [CrossRef]
- Valdés, A.; Burgos, N.; Jiménez, A.; Garrigós, M.C. Natural Pectin Polysaccharides as Edible Coatings. Coatings 2015, 5, 865–886. [Google Scholar] [CrossRef]
- Caner, C.; Cansiz, Ö. Chitosan Coating Minimises Eggshell Breakage and Improves Egg Quality. J. Sci. Food Agric. 2008, 88, 56–61. [Google Scholar] [CrossRef]
- Eddin, A.S.; Tahergorabi, R. Efficacy of Sweet Potato Starch-Based Coating to Improve Quality and Safety of Hen Eggs during Storage. Coatings 2019, 9, 205. [Google Scholar] [CrossRef]
- Jones, D.R. Haugh Unit: Gold Standard of Egg Quality. National Egg Quality School Proceedings; USDA ARS: Indianapolis, IN, USA, 2012. [Google Scholar]
- Sharp, P.F.; Powell, C.K. Decrease in Internal Quality of Hen´s Eggs during Storage as Indicated by the Yolk. Ind. Eng Chem. 1930, 22, 909–910. [Google Scholar] [CrossRef]
- Sauter, E.A.; Stadelman, W.J.; Harns, V.; McLaren, B.A. Methods for Measuring Yolk Index. Poult. Sci. 1951, 30, 629–632. [Google Scholar] [CrossRef]
- ASTM E96M-10; Standard Test Methods for Water Vapor Transmission of Materials. ASTM: West Conshohocken, PA, USA, 2010.
- Yüceer, M.; Caner, C. The Effects of Ozone, Ultrasound and Coating with Shellac and Lysozyme–Chitosan on Fresh Egg during Storage at Ambient Temperature. Part II: Microbial Quality, Eggshell Breaking Strength and FT-NIR Spectral Analysis. Int. J. Food Sci. Technol. 2020, 55, 1629–1636. [Google Scholar] [CrossRef]
- Rachtanapun, P.; Homsaard, N.; Kodsangma, A.; Phongthai, S.; Leksawasdi, N.; Phimolsiripol, Y.; Seesuriyachan, P.; Chaiyaso, T.; Chotinan, S.; Jantrawut, P.; et al. Effects of Storage Temperature on the Quality of Eggs Coated by Cassava Starch Blended with Carboxymethyl Cellulose and Paraffin Wax. Poult. Sci. 2022, 101, 101509. [Google Scholar] [CrossRef]
- Pham, T.T.; Baranyai, L.; Dam, M.S.; Ha, N.T.T.; Nguyen, L.L.P.; Varga-Tóth, A.; Németh, C.; Friedrich, L. Evaluation of Shelf Life of Egg Treated with Edible Coating by Means of NIR Spectroscopy and Laser Induced Diffuse Reflectance Imaging. J. Food Eng. 2023, 358, 111688. [Google Scholar] [CrossRef]
- Feddern, V.; De Prá, M.C.; Mores, R.; Da, R.; Nicoloso, S.; Coldebella, A.; Giovanni De Abreu, P. Egg Quality Assessment at Different Storage Conditions, Seasons and Laying Hen Strains Avaliação Da Qualidade Do Ovo Em Diferentes Condições de Armazenamento, Estações Do Ano e Linhagens de Poedeiras. Ciência Agrotecnologia 2017, 41, 322–333. [Google Scholar] [CrossRef]
- da S. Oliveira, G.; dos Santos, V.M.; Rodrigues, J.C.; Santana, Â.P. Conservation of the Internal Quality of Eggs Using a Biodegradable Coating. Poult. Sci. 2020, 99, 7207–7213. [Google Scholar] [CrossRef]
- Jones, D.R.; Ward, G.E.; Regmi, P.; Karcher, D.M. Impact of Egg Handling and Conditions during Extended Storage on Egg Quality. Poult. Sci. 2018, 97, 716–723. [Google Scholar] [CrossRef] [PubMed]
- Duman, M.; Şekeroğlu, A.; Yıldırım, A.; Eleroğlu, H.; Camcı, O. Relation between Egg Shapr Index and Egg Quality Characteristics. Eur. Poult. Sci. 2016, 80. [Google Scholar] [CrossRef]
- Sheng, L.; Wang, J.; Huang, M.; Xu, Q.; Ma, M. The Changes of Secondary Structures and Properties of Lysozyme along with the Egg Storage. Int. J. Biol. Macromol. 2016, 92, 600–606. [Google Scholar] [CrossRef] [PubMed]
- Sheng, L.; Huang, M.; Wang, J.; Xu, Q.; Hammad, H.H.M.; Ma, M. A Study of Storage Impact on Ovalbumin Structure of Chicken Egg. J. Food Eng. 2018, 219, 1–7. [Google Scholar] [CrossRef]
- Aziz, M.S.A.; Salama, H.E. International Journal of Biological Macromolecules Development of Alginate-Based Edible Coatings of Optimized UV-Barrier Properties by Response Surface Methodology for Food Packaging Applications. Int. J. Biol. Macromol. 2022, 212, 294–302. [Google Scholar] [CrossRef] [PubMed]
- Malfatti, L.H.; Zampar, A.; Galvão, A.C.; da Silva Robazza, W.; Boiago, M.M. Evaluating and Predicting Egg Quality Indicators through Principal Component Analysis and Artificial Neural Networks. LWT 2021, 148, 111720. [Google Scholar] [CrossRef]
- Li, J.; Zhu, S.; Jiang, S.; Wang, J. Prediction of Egg Storage Time and Yolk Index Based on Electronic Nose Combined with Chemometric Methods. LWT 2017, 82, 369–376. [Google Scholar] [CrossRef]
- Stadelman, W.J.; Cotterill, O.J. Egg Science and Technology, 4th ed.; Routledge: New York, NY, USA, 2013. [Google Scholar]
- Quattrocchi, A.; Freni, F.; Montanini, R.; Turrisi, S.; Zappa, E. Development, Validation and Preliminary Experiments of a Measuring Technique for Eggs Aging Estimation Based on Pulse Phase Thermography. Sensors 2022, 22, 3496. [Google Scholar] [CrossRef]
- Gautron, J.; Dombre, C.; Nau, F.; Feidt, C.; Guillier, L. Review: Production Factors Affecting the Quality of Chicken Table Eggs and Egg Products in Europe. Animal 2022, 16, 100425. [Google Scholar] [CrossRef]
- Commission Regulation (EC) No 589/2008 of 23 June 2008 Laying Down Detailed Rules for Implementing Council Regulation (EC) No 1234/2007 as Regards Marketing Standards for Eggs. Available online: https://eur-lex.europa.eu/legal-content/EN/TXT/?uri=CELEX%3A32008R0589 (accessed on 20 October 2024).
- Eke, M.O.; Olaitan, N.I.; Ochefu, J.H. Effect of Storage Conditions on the Quality Attributes of Shell (Table) Eggs. Niger. Food J. 2013, 31, 18–24. [Google Scholar] [CrossRef]
- Carraro-Alleoni, A.C. Albumen Protein and Functional Properties of Gelation and Foaming. Sci. Agric. 2006, 63, 291–298. [Google Scholar] [CrossRef]
- Noiva, R.M.; Menezes, A.C.; Peleteiro, M.C. Influence of Temperature and Humidity Manipulation on Chicken Embryonic Development. BMC Vet. Res. 2014, 10, 234. [Google Scholar] [CrossRef] [PubMed]
- Saeed, F.; Javaid, A.; Ahmed, N.; Nadeem, M.T.; Arshad, M.S.; Imran, A.; Sohaib, M.; Khan, A.U. Influence of Edible Coating Techniques on Quality Characteristics of Eggs. J. Food Process. Preserv. 2017, 41, 1–9. [Google Scholar] [CrossRef]
- Mari, A.; Fafalis, C.; Krokida, M. Evaluation of Edible Coatings from Components from Chlorella Vulgaris and Comparison with Conventional Coatings. Coatings 2024, 14, 621. [Google Scholar] [CrossRef]
- Yuan, X.; Li, Y.; Mo, Q.; Zhang, B.; Shu, D.; Sun, L.; Yang, H.; Xie, X.; Liu, Y.; Zang, Y. A Combined Approach Using Slightly Acidic Electrolyzed Water Spraying and Chitosan and Pectin Coating on the Quality of the Egg Cuticle, Prevention of Bacterial Invasion, and Extension of Shelf Life of Eggs during Storage. Food Chem. 2022, 389, 133129. [Google Scholar] [CrossRef]
- Li, L.L.; Zhang, N.N.; Gong, Y.J.; Zhou, M.Y.; Zhan, H.Q.; Zou, X.T. Effects of Dietary Mn-Methionine Supplementation on the Egg Quality of Laying Hens. Poult. Sci. 2018, 97, 247–254. [Google Scholar] [CrossRef]
- Regecová, I.; Pipová, M.; Jevinová, P.; Demjanová, S.; Semjon, B. Quality and Mycobiota Composition of Stored Eggs. Ital. J. Food Sci. 2020, 32, 540–561. [Google Scholar] [CrossRef]
- Cabanillas-Beltrán, H.; González-Estrada, R.R.; Gutiérrez-Martínez, P.; Hernández-López, S.M. Quality and Microbiological Protection of Table Eggs by Ultrasonic Application of Acidic Electrolyzed Water and Chitosan. Acta Agron. 2020, 69, 97–105. [Google Scholar] [CrossRef]
- Upadhyaya, I.; Yin, H.B.; Surendran Nair, M.; Chen, C.H.; Lang, R.; Darre, M.J.; Venkitanarayanan, K. Inactivation of Salmonella Enteritidis on Shell Eggs by Coating with Phytochemicals. Poult. Sci. 2016, 95, 2106–2111. [Google Scholar] [CrossRef]

| Formulation | Polymer (w/v %) | Protein (w/v %) | Plasticizer (w/v %) | |||||||||
|---|---|---|---|---|---|---|---|---|---|---|---|---|
| Chitosan | Aloe | Starch | Pectin | Alginate | CMC | Amylo | Gelatin | Casein | Whey | Sor | Gly | |
| F1 | 3 | - | - | - | - | - | 1 | - | 3 | - | 2.5 | - |
| F2 | 3 | - | - | - | - | - | 3 | - | 3 | - | 2.5 | - |
| F3 | 2 | - | 2 | - | - | - | - | - | - | 2 | - | 2.5 |
| F4 | 2 | - | - | - | - | - | - | 1 | - | - | 2 | - |
| F5 | 2 | - | - | - | - | - | - | - | - | 2 | 2.5 | - |
| F6 | 2.5 | - | - | - | - | - | - | - | - | - | 0.25 | - |
| F7 | 1 | 0.5 | - | - | - | - | - | 0.5 | - | - | - | 2 |
| F8 | 1 | 0.5 | - | - | - | - | - | 0.5 | - | - | 1 | - |
| F9 | 1 | 1 | - | - | - | - | - | 0.5 | - | - | - | 2 |
| F10 | 1 | 1 | - | - | - | - | - | 0.5 | - | - | 1 | - |
| F11 | 1 | 1 | - | - | - | - | - | - | - | - | - | 2 |
| F12 | 1 | 1 | - | - | - | - | - | - | - | - | 1 | - |
| F13 | - | - | - | 0.75 | - | - | - | 0.5 | - | - | - | 2 |
| F14 | - | - | - | 0.75 | - | - | - | 0.5 | - | - | 1 | - |
| F15 | - | - | - | - | 0.75 | - | 0.5 | 0.5 | - | - | 1 | 1 |
| F16 | - | - | - | - | 0.75 | - | 0.5 | 0.5 | - | - | 1 | - |
| F17 | - | - | - | - | 0.5 | - | 0.5 | 0.5 | - | - | - | 2 |
| F18 | - | - | - | - | 0.5 | - | 0.5 | 0.5 | - | - | 1 | - |
| F19 | - | - | 0.5 | - | 0.75 | - | - | 0.5 | - | - | - | 2 |
| F20 | - | - | 0.3 | - | 0.5 | - | - | 0.5 | - | - | - | 2 |
| F21 | - | - | 0.75 | - | 0.75 | - | - | 0.5 | - | - | - | 2 |
| F22 | - | - | 0.75 | - | 0.5 | - | - | 0.5 | - | - | 1 | 1 |
| F23 | - | - | - | - | - | 0.75 | 0.5 | 0.5 | - | - | 0.8 | - |
| F24 | - | - | - | - | - | 0.75 | 0.5 | 0.5 | - | - | 1 | - |
| F25 | - | - | - | - | - | 0.5 | 0.5 | 0.5 | - | - | - | 2 |
| F26 | - | - | - | - | - | 0.5 | 0.5 | 0.5 | - | - | 1 | - |
| F27 | - | - | - | - | 0.75 | - | - | 0.5 | - | - | - | 2 |
| F28 | - | - | - | - | 0.75 | - | - | 0.5 | - | - | 1 | - |
| F29 | - | - | - | - | 0.5 | - | - | 0.5 | - | - | - | 2 |
| F30 | - | - | - | - | 0.5 | - | - | 0.5 | - | - | 1 | - |
| F31 | - | - | - | - | - | 0.75 | - | 0.5 | - | - | - | 2 |
| F32 | - | - | - | - | - | 0.5 | - | 0.5 | - | - | - | 2 |
| Treatment | 4 °C | 25 °C | ||||
|---|---|---|---|---|---|---|
| Week 1 | Week 3 | Week 6 | Week 1 | Week 3 | Week 6 | |
| CT | 67.0 ± 14 b,A | 60.6 ± 7.5 b,A | 60.9 ± 1.3 b,A | 58.2 ± 6.79 ab,A | 34.4 ± 7.8 cd,B | 29.7 ± 8 d,B |
| F3 | 72.1 ±1.8 b,A | 67.1 ± 6.3 b,A | 62 ± 1.1 b,A | 59.8 ± 2.2 ab,A | 52.4 ± 3.6 bc,A | 50.2 ± 2 c,A |
| F4 * | 83.2 ± 1.7 a,A | 74.3 ± 5.7 ab,A | 74.6 ± 1.9 ab,A | 70.2 ± 1.6 a,A | 68.9 ± 11.6 a,A | 62.4 ± 1.6 ab,A |
| F8 | 69.7 ±4.2 b,A | 64.0 ± 5.4 ab,A | 69.6 ± 1.5 ab,A | 60.5 ± 1.6 ab,A | 50.5 ± 3.1 bc,AB | 45.1 ± 4.7 cd,B |
| F9 | 74.6 ±5.1 ab,A | 73.6 ± 5 ab,A | 65.6 ± 1.1 b,A | 52.2 ± 3.3 b,A | 39.3 ± 1.1 cd,B | 19.0 ± 3.7 e,C |
| F13 | 75.7 ±5.3 ab,A | 68 ± 8.3 ab,A | 67.3 ± 3.2 ab,A | 56.2 ± 5.6 ab,A | 49.7 ± 3.6 c,A | 53.2 ± 5.9 c,A |
| F14 | 70.9 ± 1.5 ab,A | 66.2 ± 0.4 ab,A | 63.6 ± 9.6 b,A | 59.7 ± 2.1 ab,A | 47.7 ± 3 c,B | 34.6 ± 0.7 d,C |
| F15 | 72.9 ±3.8 ab,A | 71 ± 6 b,A | 69.2 ± 1.6 ab,A | 75.4 ± 1.7 a,A | 54.3 ± 5.5 b,B | 49.3 ± 1.3 c,B |
| F20 * | 78.0 ±2.3 ab,A | 79.2 ± 5.4 a,A | 68.7 ± 1.7 ab,A | 68.9 ± 9.1 a,A | 55.4 ± 7.4 bc,B | 61.7 ± 10.5 bc,AB |
| F26 | 69.4 ± 2.8 b,A | 68.4 ± 1.8 ab,A | 65.1 ± 4.9 b,A | 54.7 ± 5.3 b,A | 47.9 ± 0.4 cd,A | 39.9 ± 0.6 cd,B |
| F29 | 68.3 ±9.4 b,A | 67.4 ± 5.4 ab,A | 67.9 ± 1.2 ab,A | 68.5 ± 7.7 a,A | 59.8 ± 3.2 ab,AB | 51.8 ± 3.9 c,B |
| F32 | 78.6 ± 2.1 a,A | 72.6 ± 1.9 ab,A | 69.7 ± 2.1 ab,A | 59.6 ± 1.1 ab,A | 52.4 ± 3.1 bc,A | 28.5 ± 7.8 d,B |
| Treatment | 4 °C | 25 °C | ||||
|---|---|---|---|---|---|---|
| Week 1 | Week 3 | Week 6 | Week 1 | Week 3 | Week 6 | |
| CT | 0.44 ± 0.03 ab,A | 0.37 ± 0.02 ab,A | 0.38 ± 0.01 ab,A | 0.26 ± 0.01 b,A | 0.20 ± 0.01 b,AB | 0.15 ± 0.01 b,B |
| F3 | 0.43 ± 0.02 a,A | 0.32 ± 0.05 ab,B | 0.37 ± 0.06 ab,B | 0.36 ± 0.02 a,A | 0.32 ± 0.01 ab,AB | 0.22 ± 0.01 ab,B |
| F4 | 0.43 ± 0.03 a,A | 0.42 ± 0.01 ab,A | 0.39 ± 0.01 ab,A | 0.30 ± 0 ab,A | 0.32 ± 0.04 ab,A | 0.27 ± 0.04 ab,A |
| F8 | 0.39 ± 0.01 ab,B | 0.39 ± 0.06 ab,A | 0.36 ± 0.01 ab,A | 0.36 ± 0.05 a,A | 0.28 ± 0.07 ab,AB | 0.22 ± 0.07 b,B |
| F9 | 0.39 ± 0.02 ab,B | 0.40 ± 0.009 a,A | 0.31 ± 0.02 b,A | 0.32 ± 0.02 ab,A | 0.21 ± 0.01 b,A | 0.22 ± 0.01 ab,A |
| F13 | 0.44 ± 0.05 ab,A | 0.39 ± 0.04 ab,A | 0.44 ± 0.02 a,A | 0.39 ± 0.03 a,A | 0.32 ± 0.01 ab,A | 0.23 ± 0.01 ab,B |
| F14 | 0.39 ± 0 ab,B | 0.31 ± 0.01 ab,A | 0.32 ± 0.06 b,A | 0.30 ± 0.0 ab,A | 0.21 ± 0.04 b,AB | 0.16 ± 0.04 b,B |
| F15 | 0.41 ± 0.02 ab,A | 0.44 ± 0.008 a,A | 0.43 ± 0.01 a,A | 0.33 ± 0.03 ab,A | 0.27 ± 0.03 ab,A | 0.31 ± 0.03 ab,A |
| F20 | 0.48 ± 0.02 a,A | 0.40 ± 0.03 ab,A | 0.42 ± 0.004 a,A | 0.37 ± 0.03 a,A | 0.35 ± 0.01 a,A | 0.30 ± 0.01 ab,A |
| F26 | 0.44 ± 0.01 ab,A | 0.41 ± 0.01 ab,A | 0.39 ± 0.01 ab,A | 0.33 ± 0.03 ab,A | 0.28 ± 0.01 ab,AB | 0.17 ± 0.01 b,B |
| F29 | 0.42 ± 0.01 ab,A | 0.44 ± 0.05 a,A | 0.40 ± 0.03 a,A | 0.33 ± 0.04 ab,A | 0.30 ± 0.03 ab,A | 0.25 ± 0.01 ab,A |
| F32 | 0.41 ± 0.01 ab,A | 0.38 ± 0.01 ab,A | 0.39 ± 0.01 ab,A | 0.33 ± 0.02 ab,A | 0.28 ± 0.01 ab,AB | 0.22 ± 0.01 ab,B |
| Treatment | 4 °C | 25 °C | ||||
|---|---|---|---|---|---|---|
| Week 1 | Week 3 | Week 6 | Week 1 | Week 3 | Week 6 | |
| CT | 0.0 ± 0.0 a,C | 3.18 ± 0.04 a,B | 6.62 ± 0.52 a,A | 3.39 ± 0.17 b,C | 7.31 ± 0.49 b,B | 11.12 ± 1.23 a,A |
| F3 | 0.0 ± 0.0 a,C | 2.00 ± 0.01 b,B | 6.7 ± 0.41 a,A | 2.89 ± 0.03 c,C | 4.59 ± 0.42 de,B | 9.02 ± 1.06 b,A |
| F4 | 0.0 ± 0.0 a,C | 0.25 ± 0.35 d,B | 2.74 ± 0.98 e,A | 2.96 ± 0.01 c,B | 5.85 ± 0.70 c,A | 5.66 ± 1.13 e,A |
| F8 | 0.0 ± 0.0 a,C | 0.95 ± 1.34 c,B | 5.16 ± 1.21 bc,A | 3.76 ± 0.06 ab,B | 4.72 ± 0.13 d,B | 9.26 ± 1.47 b,A |
| F9 | 0.0 ± 0.0 a,B | 0.07 ± 0.09 e,B | 5.82 ± 1.51 b,A | 3.16 ± 0.06 bc,C | 5.01 ± 0.57 d,B | 7.96 ± 1.64 c,A |
| F13 | 0.0 ± 0.0 a,B | 0.0 ± 0.00 e,B | 3.45 ± 0.66 de,A | 3.22 ± 0.44 b,B | 7.05 ± 0.02 b,A | 8.81 ± 1.52 bc,A |
| F14 | 0.0 ± 0.0 a,C | 1.89 ± 0.42 b,B | 6.97 ± 0.90 a,A | 3.73 ± 0.39 ab,C | 8.12 ± 0.87 a,B | 10.87 ± 0.68 ab,A |
| F15 | 0.0 ± 0. 0 a,B | 0.0 ± 0.0 e,B | 2.69 ± 1.08 e,A | 3.05 ± 0.08 c,B | 4.82 ± 0.09 d,B | 8.12 ± 1.58 c,A |
| F20 | 0.0 ± 0.0 a,B | 0.0 ± 0.0 e,B | 4.74 ± 2.09 c,A | 4.38 ± 0.05 a,B | 5.01 ± 0.17 d,AB | 6.4 ± 1.35 d,A |
| F26 | 0.0 ± 0.0 a,B | 0.0 ± 0.0 e,B | 4.37 ± 0.26 cd,A | 2.14 ± 0.04 cd,C | 5.03 ± 1.17 d,B | 8.34 ± 0.28 c,A |
| F29 | 0.0 ± 0.0 a,C | 0.71 ± 1.01 c,B | 4.50 ± 1.33 c,A | 0.00 ± 0.00 d,C | 3.99 ± 1.40 e,B | 6.00 ± 0.01 de,A |
| F32 | 0.0 ± 0.0 a,B | 0.0 ± 0.00 e,B | 3.47 ± 0.64 d,A | 3.93 ± 0.11 a,C | 5.34 ± 0.89 cd,B | 10.12 ± 1.89 ab,A |
| Treatment | 4 °C | 25 °C | ||||
|---|---|---|---|---|---|---|
| Week 1 | Week 3 | Week 6 | Week 1 | Week 3 | Week 6 | |
| CT | 6.04 ± 0.09 a,A | 6.34 ± 0.23 a,A | 6.37 ± 0.25 a,A | 5.93 ± 0.06 a,A | 6.54 ± 0.16 a,B | 6.52 ± 0.04 a,B |
| F3 | 6.00 ± 0.02 a,A | 6.35 ± 0.09 a,A | 5.95 ± 0.07 a,A | 6.01 ± 0.01 a,A | 6.46 ± 0.06 a,B | 6.35 ± 0.15 a,B |
| F4 | 5.93 ± 0.10 a,A | 6.15 ± 0.20 a,A | 6.03 ± 0.04 a,A | 5.91 ± 0.06 a,A | 6.22 ± 0.19 a,A | 6.15 ± 0.03 a,A |
| F8 | 6.02 ± 0.02 a,A | 6.13 ± 0.10 a,A | 6.33 ± 0.30 a,A | 6.04 ± 0.04 a,A | 6.30 ± 0.03 a,AB | 6.43 ± 0.03 a,B |
| F9 | 6.02 ± 0.02 a,A | 6.23 ± 0.03 a,A | 6.13 ± 0.13 a,A | 6.05 ± 0.02 a,A | 6.30 ± 0.05 a,AB | 6.83 ± 0.01 a,B |
| F13 | 6.03 ± 0.16 a,A | 6.35 ± 0.11 a,A | 5.98 ± 0.05 a,A | 5.99 ± 0.12 a,A | 6.37 ± 0.06 a,AB | 6.59 ± 0.19 a,B |
| F14 | 6.01 ± 0.02 a,A | 6.30 ± 0.03 a,A | 6.31 ± 0.42 a,A | 6.03 ± 0.01 a,A | 6.49 ± 0.10 a,A | 6.35 ± 0.12 a,A |
| F15 | 5.96 ± 0.09 a,A | 6.15 ± 0.19 a,A | 6.14 ± 0.02 a,A | 5.99 ± 0.27 a,A | 6.20 ± 0.20 a,A | 6.35 ± 0.18 a,A |
| F20 | 6.28 ± 0.15 a,A | 6.31 ± 0.04 a,A | 6.07 ± 0.03 a,A | 6.41 ± 0.19 a,A | 6.34 ± 0.22 a,A | 6.33 ± 0.16 a,A |
| F26 | 5.91 ± 0.03 a,A | 6.40 ± 0.05 a,A | 6.01 ± 0.01 a,A | 6.05 ± 0.06 a,A | 6.49 ± 0.06 a,AB | 6.69 ± 0.21 a,B |
| F29 | 5.96 ± 0.06 a,A | 5.91 ± 0.07 a,A | 6.07 ± 0.03 a,A | 5.94 ± 0.09 a,A | 6.15 ± 0.15 a,AB | 6.45 ± 0.36 a,B |
| F32 | 5.97 ± 0.03 a,A | 6.20 ± 0.08 a,A | 6.59 ± 0.42 a,A | 6.07 ± 0.03 a,A | 6.31 ± 0.03 a,A | 6.39 ± 0.08 a,A |
| Treatment | 4 °C | 25 °C | ||||
|---|---|---|---|---|---|---|
| Week 1 | Week 3 | Week 6 | Week 1 | Week 3 | Week 6 | |
| CT | 9.38 ± 0.18 a,A | 9.39 ± 0.12 a,A | 9.22 ± 0.01 a,A | 9.25 ± 0.53 ab,A | 9.53 ± 0.01 a,A | 9.47 ± 0.06 a,A |
| F3 | 9.06 ± 0.05 ab,a | 9.25 ± 0.04 ab,A | 9.22 ± 0.04 a,A | 9.14 ± 0.03 ab,A | 9.39 ± 0.05 ab,A | 9.13 ± 0.05 ab,A |
| F4 | 9.09 ± 0.17 ab,A | 9.0 ± 0.08 ab,A | 9.04 ± 0.06 a,A | 9.06 ± 0.26 ab,A | 8.69 ± 0.1 b,B | 9.03 ± 0.03 ab,A |
| F8 | 9.32 ± 0.07 a,A | 9.40 ± 0.05 a,A | 9.24 ± 0.01 a,A | 9.46 ± 0.07 a,A | 9.53 ± 0.04 a,A | 9.38 ± 0.1 ab,A |
| F9 | 9.16 ± 0.11 ab,A | 9.23 ± 0.04 ab,A | 9.20 ± 0.04 a,A | 9.37 ± 0.04 ab,A | 9.43 ± 0.03 ab,A | 9.42 ± 0.03 ab,A |
| F13 | 9.05 ± 0.15 a,A | 8.93 ± 0.12 b,A | 9.12 ± 0.08 a,A | 8.70 ± 0.30 b,B | 8.95 ± 0.4 ab,AB | 9.45 ± 0.01 a,A |
| F14 | 9.39 ± 0.02 a,A | 9.35 ± 0.05 a,A | 9.15 ± 0.05 a,A | 9.43 ± 0.06 a,A | 9.47 ± 0.07 a,A | 9.42 ± 0.1 a,A |
| F15 | 9.34 ± 0.06 a,A | 9.13 ± 0.23 ab,A | 9.10 ± 0.13 a,A | 9.27 ± 0.15 ab,A | 9.17 ± 0.09 ab,AB | 8.96 ± 0.3 b,B |
| F20 | 8.23 ± 0.06 b,B | 8.97 ± 0.13 b,AB | 9.18 ± 0.01 a,A | 8.59 ± 0.35 b,A | 8.49 ± 0.65 b,A | 8.91 ± 0.1 b,A |
| F26 | 9.23 ± 0.15 ab,A | 9.39 ± 0.08 a,A | 9.10 ± 0.02 a,A | 9.34 ± 0.07 a,A | 9.48 ± 0.06 ab,A | 9.32 ± 0.02 ab,A |
| F29 | 9.12 ± 0.35 ab,A | 9 ± 0.21 b,A | 9.06 ± 0.16 a,A | 9.01 ± 0.21 ab,AB | 8.85 ± 0.2 ab,B | 9.3 ± 0.09 ab,A |
| F32 | 9.21 ± 0.03 ab,A | 9.3 ± 0.04 ab,A | 9.14 ± 0.0 a,A | 9.28 ± 0.02 ab,A | 9.38 ± 0.02 ab,A | 9.23 ± 0.07 ab,A |
Disclaimer/Publisher’s Note: The statements, opinions and data contained in all publications are solely those of the individual author(s) and contributor(s) and not of MDPI and/or the editor(s). MDPI and/or the editor(s) disclaim responsibility for any injury to people or property resulting from any ideas, methods, instructions or products referred to in the content. |
© 2024 by the authors. Licensee MDPI, Basel, Switzerland. This article is an open access article distributed under the terms and conditions of the Creative Commons Attribution (CC BY) license (https://creativecommons.org/licenses/by/4.0/).
Share and Cite
Cortés-Ramírez, G.S.; Velasco, J.I.; Plascencia, M.Á.; Absalón, Á.E.; Cortés-Espinosa, D.V. Development of Edible Coatings Based on Different Biopolymers to Enhance the Internal Shelf-Life Quality of Table Eggs. Coatings 2024, 14, 1525. https://doi.org/10.3390/coatings14121525
Cortés-Ramírez GS, Velasco JI, Plascencia MÁ, Absalón ÁE, Cortés-Espinosa DV. Development of Edible Coatings Based on Different Biopolymers to Enhance the Internal Shelf-Life Quality of Table Eggs. Coatings. 2024; 14(12):1525. https://doi.org/10.3390/coatings14121525
Chicago/Turabian StyleCortés-Ramírez, Georgina S., J. I. Velasco, Miguel Ángel Plascencia, Ángel E. Absalón, and Diana V. Cortés-Espinosa. 2024. "Development of Edible Coatings Based on Different Biopolymers to Enhance the Internal Shelf-Life Quality of Table Eggs" Coatings 14, no. 12: 1525. https://doi.org/10.3390/coatings14121525
APA StyleCortés-Ramírez, G. S., Velasco, J. I., Plascencia, M. Á., Absalón, Á. E., & Cortés-Espinosa, D. V. (2024). Development of Edible Coatings Based on Different Biopolymers to Enhance the Internal Shelf-Life Quality of Table Eggs. Coatings, 14(12), 1525. https://doi.org/10.3390/coatings14121525

